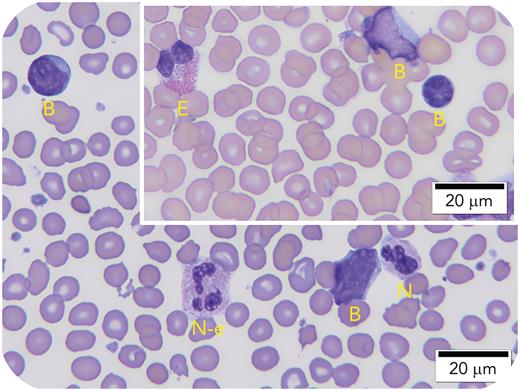
graphic

A 4-day-old boy with trisomy 21 was admitted for evaluation of jaundice. A complete blood cell count performed at admission showed the following: white blood cell (WBC) count, 17.7 × 109/L; hemoglobin, 1330 mg/L; and platelets, 434 × 109/L. Review of a stained peripheral blood smear showed the differential cell count: blasts, 27%; neutrophils, 41%; lymphocytes, 26%; monocytes, 3%; eosinophils, 2%; and basophils, 1%. Furthermore, 2 populations of neutrophils, almost equal in number, were noted: one showing the usual azurophilic/violet granules (100× objective; N) and the other population exhibiting exclusively dotlike pink granules (N-e). These granules are smaller when compared with the granules of the child’s eosinophils (inset; E). Cell marker study by flow cytometry confirmed the presence of a blast population expressing CD38, CD34 (partial), CD45 (dim), CD4 (dim), CD56 (partial), CD7 (partial), CD117, CD 41 (bright), and cytoplasmic CD61 (partial), supporting the impression of transient abnormal myelopoiesis of Down syndrome. By flow cytometry, eosinophils constituted 2% of WBCs. Myeloid mutation panel by next-generation sequencing performed on peripheral blood found GATA1 c.220G>T, p. Val74Phe mutation in 55% of cells.
The role of GATA1 in hematopoietic cell development into eosinophils and neutrophils is well established. However, a visual demonstration connecting a mutated GATA1 gene to such an unusual and distinct morphologic variant of neutrophils, as illustrated in this case, has not been described and warrants further exploration.
For additional images, visit the ASH Image Bank, a reference and teaching tool that is continually updated with new atlas and case study images. For more information, visit https://imagebank.hematology.org.
This feature is available to Subscribers Only
Sign In or Create an Account Close Modal